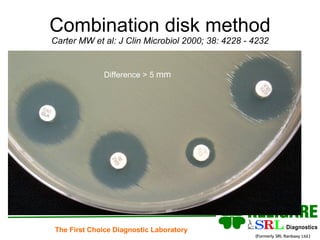
Combination disk method Carter MW et al: J Clin Microbiol 2000; 38: 4228 - 4232 Difference > 5  mm
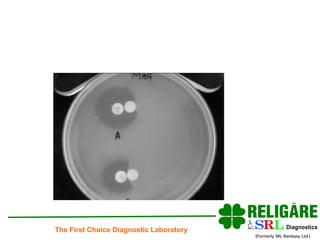
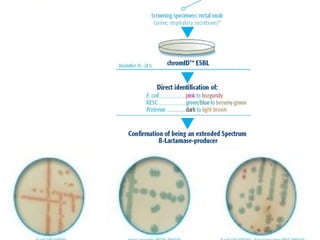
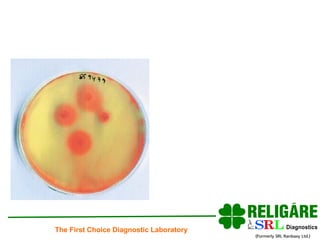

The document discusses extended spectrum beta-lactamases (ESBL), emphasizing their evolution, classification, detection methods, and clinical implications in treating infections caused by resistant bacteria. It highlights the importance of laboratory detection and appropriate antibiotic use, particularly avoiding third and fourth-generation cephalosporins for ESBL-producing organisms. Additionally, it outlines various therapeutic options and the significance of effective infection control measures in healthcare settings.